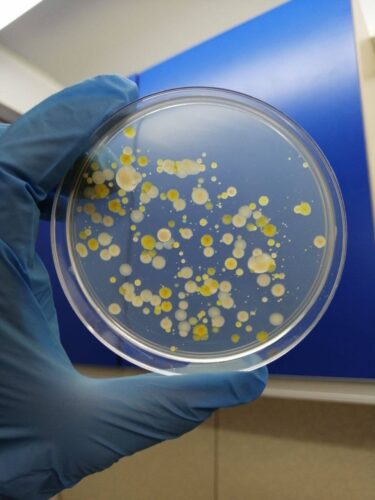

Related posts
-
Учені Національного антарктичного наукового центру візьмуть участь у проєкті ЄС про полярний сніг та вічну мерзлоту
Національний антарктичний науковий центр став учасником нового проєкту ЄС «Полярний сніг, вічна мерзлота і материковий лід у... -
Імператорські пінгвіни та антарктичні морські котики під загрозою зникнення
Міжнародний союз охорони природи офіційно оголосив імператорських пінгвінів та антарктичних морських котиків видами, які перебувають під... -
Міністерство освіти і науки України планує створення Морського центру досліджень
МОН готує запуск Морського центру досліджень, повідомив заступник міністра Денис Курбатов. За його словами, планується об’єднати...